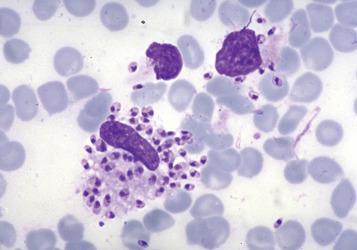

L’environnement englobe les éléments naturels et artificiels qui entourent les êtres vivants, comme l’air, l’eau, les sols et les écosystèmes. Le développement durable est un modèle qui vise à répondre aux besoins du présent sans compromettre les générations futures, en équilibrant les piliers économique, social et environnemental. Son objectif est de préserver les ressources naturelles, protéger la biodiversité, lutter contre les changements climatiques, et promouvoir une justice sociale et économique pour un avenir durable.
- Enseignant: Houria Tadjouri

La mycologie est une branche essentielle de la biologie qui s'intéresse à l'étude des champignons. Ces organismes, longtemps négligés, jouent pourtant un rôle crucial dans de nombreux écosystèmes et ont des impacts directs et indirects sur la santé humaine, animale,,végétale et sur les industries agroalimentaires et pharmaceutiques.
Ce cours intitulé « Mycologie » a pour objectif d’initier les étudiants aux bases de la science mycologique, en abordant à la fois les aspects fondamentaux et appliqués. À travers les différentes unités d'apprentissage, le cours permettra d'explorer la diversité taxonomique des champignons, leurs modes de reproduction, leurs rôles écologiques, ainsi que leurs interactions avec l’homme, en tant qu’agents pathogènes ou producteurs de substances toxiques (mycotoxines).
Ce cours mettra également l'accent sur les particularités des champignons d'intérêt médical, en
abordant les mécanismes de pathogénicité, les différentes formes de mycoses, ainsi que les risques liés aux moisissures opportunistes dans des contextes spécifiques comme l'immunodépression.
Il permettra aux étudiants de découvrir les enjeux de santé publique associés aux contaminations fongiques, d’identifier les espèces les plus importantes en mycologie médicale et de comprendre les stratégies de lutte et de prévention.
Le cours est structuré en un ensemble d’unités d’apprentissage visant à développer chez l’étudiant des compétences en identification, classification, compréhension des risques sanitaires liés aux champignons, et élargir ses connaissances aux applications de la mycologie dans différents secteurs.
- Enseignant: meriem meliani

Le cours microbiologie 2 destiné aux étudiants de 2ème année tronc commun, ingénieur en agronomie se concentre sur l’étude des micro-organismes (champignons, virus, microalgues) sur le plan structural, physiologique, taxonomique et le mode de reproduction, les agents antimicrobiens utilisés pour lutter contre les micro-organismes qui peuvent causer des problèmes de santé et l’utilisation des micro-organismes dans divers domaines en particulier dans le domaine agroalimentaire.
- Enseignant: Youcef benaissa kaddar

Le module "Environnement et Développement Durable" aborde les liens complexes entre les activités humaines et l'environnement, en mettant l'accent sur la nécessité de concilier développement économique, progrès social et protection de l'écosystème. L'objectif est de sensibiliser à l'importance d'une approche durable, qui répond aux besoins du présent sans compromettre ceux des générations futures.
- Enseignant: Ayoub ALLAM
Les Parasitoses, infections causées par des Parasites (Protozoaires, Helminthes) représentent un enjeu majeur de santé publique, particulièrement dans les régions tropicales et subtropicales. Leur diagnostic précis est essentiel pour une prise en charge efficace, la prévention des complications et le contrôle épidémiologique.
Ce module abordera les méthodes de diagnostic des parasitoses, incluant :
- Techniques Microscopiques : Examen direct, coloration ;
- Méthodes immunologiques et outils de biotechnologie ;
- Diagnostic sérologiques et moléculaires (PCR ; ELIZA) ;
- Diagnostic différentiels et interprétation de résultats.
- Dr.: mahmoud adel chabane
Ce cours "Pharmacologie & Toxicologie" constitue une Unité d’Enseignement Fondamentale destinée aux étudiants du 3 -ème année Licence spécialité Biochimie. Ce module a pour objectif de fournir aux apprenants les principes de base nécessaires pour l’étude des mécanismes d’action des médicaments et des toxiques, en intégrants à la fois les aspects théoriques et pratiques liés à leur utilisation. Il permet d’acquérir les connaissances fondamentales nécessaires pour comprendre les interactions entre les substances chimiques ou naturelles et l’organisme vivant. Le module permet également à l'apprenant, à travers des exemples concrets, d’associer les connaissances de biochimie à des applications pratiques en lien avec le domaine pharmaco-toxicologique.
- Dr: Leila Kebal

Ce cours est dédié au étudiants de 3ème année Licence, spécialité "technologies des industries agro-alimentaires et contrôle de qualité TIAA". Ce module d’informatique vise à doter les apprenants des bases essentielles pour comprendre et utiliser un ordinateur, alliant théorie et pratique.

- Enseignant: amina nour el houda saibi

Le présent cours de biologie végétale 01constitue une Unité d’Enseignement Fondamentale du 1èr semestre de la 1ère année cycle Ingénieur en Agronomie, fait partie intégrante des Sciences du Vivant, cette discipline permet d’acquérir des connaissances concernant une introduction à la biologie végétale, la morphologie des végétaux supérieurs et les différents types de tissus végétaux.
- Enseignant: nouar belgacem